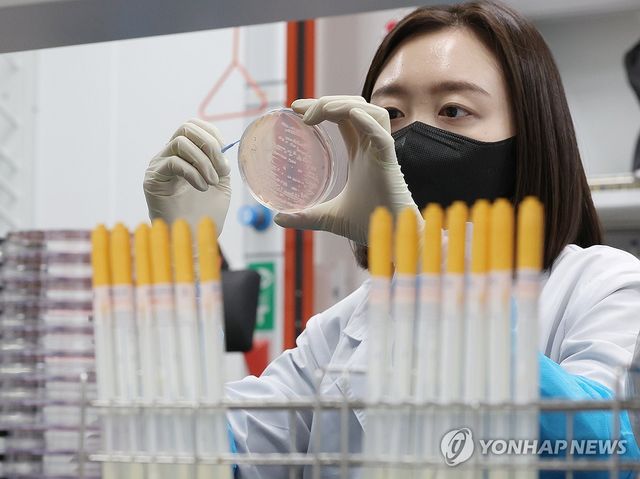
식중독균 배양분리작업 시연

(울산=연합뉴스) 김근주 기자 = 울산보건환경연구원은 올해 상반기 울산에서 발생한 식중독이 총 6건으로, 지난해 상반기(12건)보다 50% 줄었다고 21일 밝혔다.
올 상반기 식중독은 모두 노로바이러스 감염으로, 세균성 식중독은 한 건도 발생하지 않았다.
보건환경연구원은 지난해 겨울부터 가동 중인 계절별 맞춤형 감시체계가 효과를 본 것으로 풀이했다.
울산시는 계절별 맞춤형 감시체계를 통해 10월부터 이듬해 3월까지는 노로바이러스 등 겨울철 바이러스성 식중독 예방에 주력하고 있다.
기온이 상승하는 4월 이후부터는 살모넬라, 병원성대장균 등 세균성 식중독 예방을 위한 감시 활동을 강화하고 있다.
보건환경연구원은 여름 휴가철을 앞두고 지난 3일부터 다중이용시설(고속도로 휴게소, 해수욕장, 놀이시설 등)을 중심으로 식품 안전성 검사를 강화하고 있다.
canto@yna.co.kr
Copyright ⓒ 연합뉴스 무단 전재 및 재배포 금지
본 콘텐츠는 뉴스픽 파트너스에서 공유된 콘텐츠입니다.